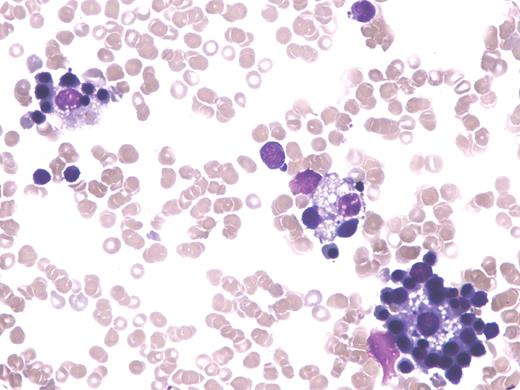
A 7-year-old girl with relapsed acute lymphoblastic leukemia had been the recipient of an unrelated donor marrow transplant 8 months earlier. After a course of dexamethasone, mercaptopurine, and methotrexate, her marrow showed a morphologic remission with 100% donor chimerism. Noteworthy were the presence of numerous erythroblastic islands (pictured). / Erythroblastic islands are rosettes consisting of a centrally located macrophage surrounded by at least one layer of developing red cell precursors. Each precursor has intimate contact with the macrophage cytoplasm. The central macrophage, termed a “nurse” cell, may support developing red cells by providing required recycled hematinics and by preventing apoptosis of the precursors via adhesive interaction between very late activation antigen 4 and vascular cell adhesion molecule 1. The excess of such islands in this case may reflect a sign of erythropoietic stress related to relative increase in sensitivity of donor hemopoiesis to thiopurine and antifolate therapy. / Previously reported to www.bloodmed.com as: “Case study Images 190: Erythroblastic islands following treatment of acute lymphoblastic leukemia.”

A 7-year-old girl with relapsed acute lymphoblastic leukemia had been the recipient of an unrelated donor marrow transplant 8 months earlier. After a course of dexamethasone, mercaptopurine, and methotrexate, her marrow showed a morphologic remission with 100% donor chimerism. Noteworthy were the presence of numerous erythroblastic islands (pictured).
Erythroblastic islands are rosettes consisting of a centrally located macrophage surrounded by at least one layer of developing red cell precursors. Each precursor has intimate contact with the macrophage cytoplasm. The central macrophage, termed a “nurse” cell, may support developing red cells by providing required recycled hematinics and by preventing apoptosis of the precursors via adhesive interaction between very late activation antigen 4 and vascular cell adhesion molecule 1. The excess of such islands in this case may reflect a sign of erythropoietic stress related to relative increase in sensitivity of donor hemopoiesis to thiopurine and antifolate therapy.
Previously reported to www.bloodmed.com as: “Case study Images 190: Erythroblastic islands following treatment of acute lymphoblastic leukemia.”
A 7-year-old girl with relapsed acute lymphoblastic leukemia had been the recipient of an unrelated donor marrow transplant 8 months earlier. After a course of dexamethasone, mercaptopurine, and methotrexate, her marrow showed a morphologic remission with 100% donor chimerism. Noteworthy were the presence of numerous erythroblastic islands (pictured).
Erythroblastic islands are rosettes consisting of a centrally located macrophage surrounded by at least one layer of developing red cell precursors. Each precursor has intimate contact with the macrophage cytoplasm. The central macrophage, termed a “nurse” cell, may support developing red cells by providing required recycled hematinics and by preventing apoptosis of the precursors via adhesive interaction between very late activation antigen 4 and vascular cell adhesion molecule 1. The excess of such islands in this case may reflect a sign of erythropoietic stress related to relative increase in sensitivity of donor hemopoiesis to thiopurine and antifolate therapy.
Previously reported to www.bloodmed.com as: “Case study Images 190: Erythroblastic islands following treatment of acute lymphoblastic leukemia.”
Many Blood Work images are provided by the ASH IMAGE BANK, a reference and teaching tool that is continually updated with new atlas images and images of case studies. For more information or to contribute to the Image Bank, visit www.ashimagebank.org.